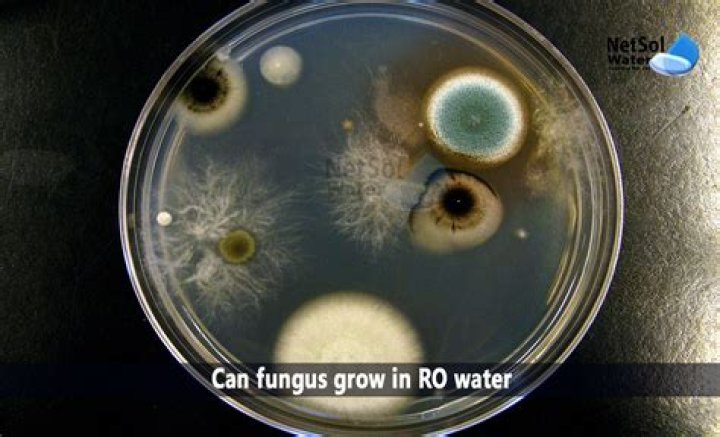

Can fungus be in well water?

Daniel Johnson
Published Mar 12, 2026
Can fungus be in well water?
A wide variety of fungi have been reported in drinking water including Acremonium, Alternaria, Aspergillus, Cladosporium, Fusarium, Penicillium and Trichoderma. Fungal contamination could explain the close correlation between distribution of well water and cases of sporadic ALS in the United States.
What happens if you drink fungus water?
Water contaminated with fungi is of importance to hospitals where immunocompromised patients undergo treatment. Fungi present in drinking water may cause severe fungal infections in immunosuppressed patients.
Can bad water cause fungal infection?
Potentially pathogenic fungal microorganisms are found in a variety of freshwater sources, including surface waters, drinking water and public bathing and swimming facilities. Fortunately, fungal infections as a result of freshwater exposure or trauma are rare.
Can well water cause ALS?
MND mortality rates and well water use in the U.S. are significantly positively associated at the level of the county. These findings extend our previous findings at the level of the state and implicate a factor present in well water as a possible environmental cause of ALS.
How do you fix contaminated well water?
Shock chlorination is the process by which home water systems such as wells, springs, and cisterns are disinfected using household liquid bleach (or chlo- rine). Shock chlorination is the most widely recommended means of treating bacterial contamination in home water systems.
Can mold grow in your lungs?
The mold spores can colonize (grow) inside lung cavities that developed as a result of chronic diseases, such tuberculosis, emphysema, or advanced sarcoidosis. The fibers of fungus might form a lump by combining with white blood cells and blood clots.
What is the black gunk in my water bottle?
Stachybotrys chartarum, or black mold, is one of the most toxic mold species. And, if you aren’t cleaning your reusable water bottle properly, it is one of the culprits who might be living in there. Mold grows best in dark, damp environments, exactly like the environment your water bottle provides.
How do I get rid of fungus in my body?
Antifungal medications work to treat fungal infections. They can either kill fungi directly or prevent them from growing and thriving. Antifungal drugs are available as OTC treatments or prescription medications, and come in a variety of forms, including: creams or ointments.
Can Candida survive water?
Candida is a major Human pathogen causing a variety of infections and can survive for extended period of time in aquatic environment including marine and fresh water.
What is BMAA toxin?
β-methylamino-L-alanine (BMAA) is an environmental toxin that is made by some kinds of cyanobacteria, blue-green bacteria that typically live in the ocean. BMAA can accumulate in fish and shellfish that ultimately are consumed by humans. This toxic compound has been linked to the development of ALS.
What is BMAA found in?
BMAA has been found in aquatic organisms and in plants with cyanobacterial symbionts such as certain lichens, the floating fern Azolla, the leaf petioles of the tropical flowering plant Gunnera, cycads as well as in animals that eat the fleshy covering of cycad seeds, including flying foxes.



